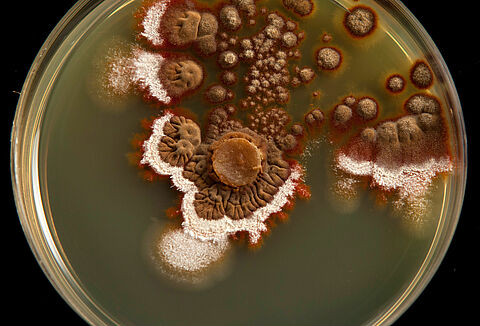
Muffa blu

Malattie comuni delle piante
Ricerca malattie delle piante
-

Virus del mosaico del pepino
Potexvirus pepini
Marciume del piede dei cereali
Microdochium nivale
Fusarium spp.
Fusarium spp.
Alternariosi
Alternaria solani
Marciume nero della carota
Alternaria radicina
Marciume molle batterico, marciume batterico dello stelo
Pectobacterium carotovorum
La malattia di Pierce della vite
Xylella fastidiosa
Maculatura angolare
Xanthomonas fragariae
Verticilliosi
Verticillium spp.
Ticchiolatura del melo
Venturia inaequalis
Carbone del frumento
Ustilago tritici
Carie del frumento
Tilletia tritici and Tilletia laevis
Marciume bianco da Sclerotinia
Sclerotinia sclerotiorum
Galla del colletto
Rhizobium spp.
Antracnosi del pisello
Ascochyta pisi
Marciume dei semenzai.
Pythium ultimum
Marciume radicale marrone, marciume radicale fibroso
Pyrenochaeta lycopersici
Oidio
Erysiphe, Podosphaera, Oidium, Leveillula spp.
Peronospora della patata e del pomodoro
Phytophthora infestans
Cancrena pedale del peperone
Phytophthora capsici
Marciume del colletto
Phytophthora cactorum
Marciume radicale delle Cucurbitacee
Phomopsis sclerotioides
Peronospora della rosa
Peronospora sparsa
Muffa blu
Penicillium italicum
Fusariosi
Fusarium oxysporum
Fusariosi della spiga o scabbia del grano
Fusarium graminearum
Cancro batterico del pomodoro
Clavibacter michiganensis
Botrite
Botrytis cinerea

















